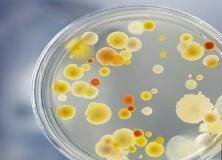
IMG ٢٠١٩٠٥٠٩ ٠٠٤٥٠٥ ٠٤١ - علماء يطورون جهازًا جديدًا لاكتشاف البكتيريا في دقائق

قد ينتهي قريبا العصر الذي يصف فيه الأطباء للمرضى المضادات الحيوية القوية أثناء انتظار نتائج الفحوص المخبرية، بفضل جهاز جديد يوفر هذه النتائج في دقائق.
وابتكر هذا الجهاز فريق طبي من جامعة ولاية بنسلفانيا، ووصف في ورقة بحثية نشرتها “الأكاديمية الوطنية للعلوم” الاثنين.
ويستخدم الجهاز الجديد تقنية متناهية الصغر تمسك خلايا بكتيريا وحيدة وتعرضها تحت مجهر إلكتروني.
